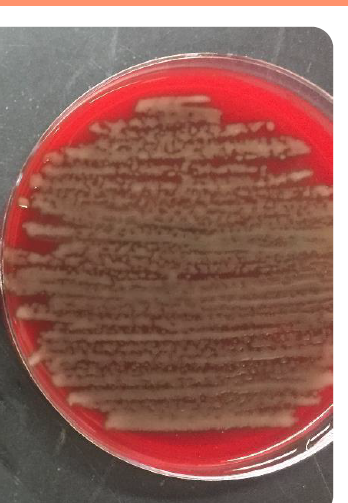

אילו מחלות זיהומיות מאפיינות דרכי נשימה עליונות (בילדים)
4
- Common cold- ויראלי
- Croup- ויראלי
- Epiglottitis- מצב חירום רפואי , יש חיסון המופילוס פארא אינפואנזה
- Bacterial tracheitis- בד”כ משני לזיהום ויראלי
מהם המאפיינים של הצטננות פשוטה
Common cold
,התייצגות קלינית,משך, סיבוכים טיפול
נזלת, שיעול ולעיתים חום. מחלה ויראלית
נמשכת בערך שבוע
ילדים מעל גיל שנה- לרוב ללא חום
ילדים מתחת לגיל שנה- בד”כ עם חום
בתינוקות בגיל חודש חודשיים- יכולים להתייצג עם הפסקות נשימה (לא יכולים לנשום דרך הפה) ויכול לפגוע ביכולת לאכול
סיבוכים:
דלקת באוזן התיכונה, דלקת ריאות, סינוסיטיס ואסטמה
טיפול
הקלה בסימפטומים
מהי
CROUP (laryngotracheobronchitis)
, מחולל התייצגות קלינית, גילאים, סיבוכים, טיפול
מחלה של חסימת דרכי אוויר עליונות , התייצגות עם שיעול נבחני, נשמע סטרידור- קול אינספירטורי בחסימה
מחולל הכי שכיח- Para-influenzas (75%)
גיל- 3 חודשים עד- 5 שנים
טיפול- אנהלציית אנדרנלין וסטרואידים להקל והורדת הדלקת המקומית
סיבוכים- זיהומים משניים
הדמייה- לא ספציפי ולא רגיש Steeple sign= צריח בקנה
מהו
Spasmodic Croup
זיהומים חוזרים של מחלות קרופ, כנראה תגובת יתר, טיפול סימפומטי עם סטרואידים. אם הילדים מאוד חולים (כחלון / ירידה בסטורציה) נבצע טיפול אגרסיבי יותר
מהו הממצא

Steeple sign
היצרות של הטרכיאה , קנה צריח
מאפיין Croup

אפיגלוטיטיס
מי המחולל העיקרי
התייצגות קלינית
מצב חירום רפואי
היום יש חיסון
Haemophilus influenzae type B
חום , כאב, גרון, הדרדרות נשימה, נשענים קדימה **אנשים עם דאון יש חסר חיסוני ולכן בסיכון ביתר

Bacterial tracheitis
התייצגות, מחולל שכיח, מהלך היסטורי
יכול להיות חלק מקרופ (זיהומים ויראליים)
בד”כ זיהום משני למחלה ויראלית-החולים נראים יותר חולים (זיהום ויראלי ילדים בד”כ נראים טוב יותר והמעבדה שקטה)
זיהום חיידקים עם חום גבוה, הפרשות מוגלתיות ושיעול מתכתי
מחולל שכיח- סטאפ. ארוס
אילו 2 מחלות עיקריות נראה בילדים בדרכי נשימה תחתונות
- ברונכיאוליטיס- אבחנה רק בילדים מתחת לגיל שנתיים
- פניאומוניה- בילדים סטרפ פניאומוניה הכי שכיח
ברונכיאוליטיס
גיל, פתופיזיולוגיה, התייצגות קלינית, מחולל שכיח, טיפול
אבחנה רק בילדים מתחת לגיל שנתיים
התייצגות קלינית- צפצופים, קוצר נשימה, טכיפניאה, נשימת כנפי אף, ריטרקציות שימוש בשרירי עזר נשימתיים בבית חזה, הבטן עובדת.
מחולל שכיח- RSV אין חיסון, יש פאסיבי לתינוקות בסיכון סביב העונות שקורה
פתופיזיולוגיה- חסימת דרכי אוויר קטנטנות (נחסמות בקלות בתינוקות הקטנים)
טיפול- זונדה (שיתרכזו בלנשום, חמצן וכדומה) ניתן לתת וונטולין וסטרואידים (לא הוכח שעוזר)
תינוק מתחת לגיל שהתחילה אצלו נזלת ותוך יום יומיים זה מתקדם והזיהום מתשפט וביום השלישי מעורבות של דרכי אוויר תחתונות, מתקשים לנשום, משתעלים, לא חייב להיות חום. בד”כ האח הגדול היה מנוזל ששואלים, האם מספרת על תסמינים המתאימים לזיהום דרכי אוויר עליונות (שיעול, נזלת
מהי האבחנה האפשרית
סיפור קלאסי לברונכיאוליטיס
וירוס מאוד מדבק ונדבקים כל שנה מחדש. במבוגרים תסמנים של URI.
RSV
קשור בהופעה של 2 מצבים ?
מה חיזק את ההשערה שיש קשר בין הווירוס למצבים הנ”ל
אסתמה וברונכיאוליטיס - לא ידוע מי הביצה ומי התרנגולת
בקורונה כל הוירוסים נעלמו - לא ראו ברונכיאוליטיס ולא התקפי אסטמה או צפצופים
בנוסף פניאומוניה והוירוס גם משפיעים אחד על השני- פיקים תואמים בתחלואה, כנראה הוירוס גורם לפניאומוקוק להיות יותר אלים
פניאומוניה
מהלך היסטורי, מחוללים, התייצגות קלינית
**וירוסים שעושים ברונכיאוליטיס יכולים גם לחולל פניאומוניה
לרוב דלקת ריאות חיידקית- שוב משנית לזיהום ויראלי (כמו טראכאיטיס בקרטריאלי)
רואים החמרה בתסמינים- שיעול יותר פרודוקטיבי, קשה לנשום , החמרה.
ילדים בגיל בית ספר- התייצגות פתאומית (יכולה להתבטא בכאבי בטן והקאות)
המחולל העיקרי הינו סטרפ. פניאומוניה (פניאומוקוק) בילדים ← ב-40% מהילדים הם נמצאים באף ולא עושים כלום, לעיתים יש טריגר שגורם לחיידק להיות אינבזיבי יותר **ילד עם פניאומוקוק חיובי מתרבית מהאף לא אומר שלילד יש פניאומוקוק

מהו הסרוטיפ שמאפיין את הפניאומוקוק
כיצד נמנע פניאומניה מפניאומוקוק
כיצד נוכל לאבחן פניאומוקוק שמחולל מחלה אינבזיבית
קפסולות
בתרבית נראה גרגור- הקפסולות
חיסון- 3 מנות עד גיל שנה ל-13 הזנים הכי אלימים
בירור מחלה אינבזיבית- אוכל לבודד מאזור סטרילי (דם , נוזל חוט שדרה)
כיצד מתחיל כל אירוע של זיהום בדרכי נשימה ?
LTRI
קולוניזציה של מחוללים באף או בגרון שמצוים שם באופן נורמלי
כיצד מתחיל כל אירוע של זיהום בדרכי נשימה ?
LTRI
קולוניזציה של מחוללים באף או בגרון שמצוים שם באופן נורמלי
מהו הממצא
איזה זיהום נראה ומדוע מתרחש

קנדידה- שמר
שוכנת באופן שגרתי בדרכי עיגול, חלל הפה ומע’ גנטילית ועור
לרוב ייגרם זיהום על רקע פגיעה במנגנוני ההגנה הטבעיים, זיהום יכול להיות שטחי או פולשני (צמיחה בדם)

מי הם החולים בסיכון לקנדידמיה
- טיפול אנטיוביטי,
- קתטר
- ניתוח אבדומינאלי
- כימותרפיה
- ליין מרכזי
- מדוכאי חיסון
- סכרתיים
מהם ההתוויות למתן טיפול אנטי-פטרייתי אמפירי
חולים קריטיים + גורמי סיכון + ללא גורם אחר למצב הספטי
כיצד נאבחן קנדידה
אבחון של קנדידה:
- תרבית מהדם
- אנטיגן לבטא די גלוקן
- PCR לקנדידה

מה יכול להגיד לנו לחץ פתיחה גבוהה בניקור מותני
עדות לזיהום
איזו פטרייה אופיינית לחולל מנינגיטיס במדוכאי חיסון
קריפטוקוקוס- שמר
מצויה בעיקר בהפרשות של עופות
, מהו הזיהום הכי שכיח של קריפטוקוקוס, באיזה חולים שכיח שיתרחש, מה מאפיין אותה, מה נראה בבדיקות מעבדה, אבחנה, טיפול
הזיהום הכי שכיח- קריפטוקוקל מנינגיטיס
CD4 < 100 (HIV)
מאפיין- לחץ תוך גולגולתי גבוהה = סיכון גבוה להרניאציה של המח
בבדיקת נוזל שדרה- לימפוציטים, חלבון גבוה וסוכר נמוך
ככל שיש יותר תאים = המחלה יותר חמורה אך באיידס זה ההפך
אבחנה-
- צביעת אינדיאה מנוזל עמוד שדרה,
- אנטיגן קריפטוקוקיאלי מהדם או מנוזל חוט השדרה,
- פאנל PCR,
- תרבית מנוזל חוט שדרה
טיפול- אנטי-פטרייתי, וניקורים חוזרים להורדת לחץ תוך גולגולתי. לא מתחילים טיפול לאיידס בשלב המחלה, נדחה בכמה שבועות כדי לא לגרום ל IRIS

מהו הממצא

פטריית עובש- מוקור
מוקורמיקוזיס
גורמי סיכון, התייצגות קלינית,טיפול, אבחנה
נגרמת מפטריית עובש סביבתית בשם מוקור ← זיהום אגרסיבי שמתקדם מערב, מערב כלי דם ויוצר נמק מצב מסכן חיים לא מוגבל ע”י רקמות **התקדמות המשכית ופחות המטוגנית
גורמי סיכון- סכרת, פגיעה בתפקוד פגוציטים (מושתלי מח עצם, טיפול מדכא חיסון), עליה ברמות ברזל חופשי בדם, ניתוח בטני או טראומה עורית מזהמת
התייצגות קלינית- מחלה סינו-צרבלרית- = סכרת, מושתלי מח עצם, מחלה ריאתית - מושתלי מח עצם, זיהום בטני, זיהום עורי
אבחנה- תרבית וביופסיה מהרקמה , אולי גם נצליח מהדם
, טיפול- ניתוח כולל הטרייה אף טיפול תרופתי לא יצליח להכחיד בנוסף טיפול אנטי-פטרייתי וטיפול במחלת הרקע



































